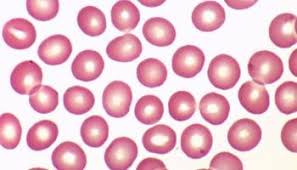
term image
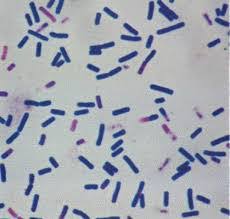
term image

Vet Tech Parasites/Organs
1/64
There's no tags or description
Looks like no tags are added yet.
Name | Mastery | Learn | Test | Matching | Spaced | Call with Kai |
|---|
No analytics yet
Send a link to your students to track their progress
65 Terms

A household fly, white larva with rings
Blowfly

Square crystals with crossing lines
Calcium Oxalate Crystals

Yellow fat larva with mouth parts and bumps all over,
Grey fly, not to be confused with horse bot
Cat Warble

Large amount of round little dots
Cocci

little circle with two circles on the inside, can be oval too, may look like a circle with a big circle if the two inside dots merge
Coccidia

Demodectic mite

Ear Mite

circular cell with 2 blobs inside, rough around the edges, usually dyed pink, not to be confused with coccidia
Eosinophils

Flea Larvae

Large circle with many small circles inside, similar to berries or a bunch of grapes
Flea Tapeworm Egg

Flea Tapeworm Segments

Flea Tapeworm

Fleas

Giardia

Heartworm

Heartworm Microflaria

Hookworm

Hookworm Egg

Horse Bots

Horse Strongyles

Lice- Biting

Lice- Sucking

Liver Fluke

Mosquito

Mosquito Larvae

Neutrophils

Platelets
Red Blood Cells (Erythrocytes)
Bacteria (Rod)

Round Worm

Round Worm Egg

Sarcoptic Mite

Struvite Crystals

Taenia Tapeworm Egg

Taenia Tapeworm Segments

Taenia Tapeworm

American Dog Tick

Black-legged Deer Tick

Brown dog Tick

Lonestar Tick

Whipworm Egg

Whipworm

Yeast

Uterine Horn/Horns

Gall Bladder

Heart

Kidney

Lungs

Ovary

Ruminant Stomach

Monogastric Stomach

Rumen

Reticulum

Omasum

Abomasum

Large Intestine

Small Intestine

Trachea

Uterus

Cervix

Cecum

Testies

Spleen

Brain

Esophagus